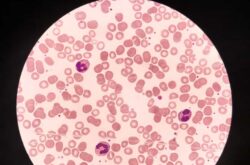

Η Αθήνα θα φιλοξενήσει το πρώτο Νοσηλευτικό Εργαστήριο για τις αιμοσφαιρινοπάθειες, μια πρωτοβουλία που ενισχύει την εκπαίδευση των επαγγελματιών υγείας και αναδεικνύει τον κρίσιμο ρόλο της νοσηλευτικής φροντίδας. Η Διεθνής Ομοσπονδία Θαλασσαιμίας και η Ελληνική Ομοσπονδία Θαλασσαιμίας ενώνουν τις δυνάμεις τους για μια διήμερη δράση με υψηλή επιστημονική αξία και ισχυρό εκπαιδευτικό αποτύπωμα.
Το εργαστήριο αφιερωμένο στη νοσηλευτική φροντίδα με τίτλο «1ο Νοσηλευτικό Εργαστήριο για τις Αιμοσφαιρινοπάθειες» θα πραγματοποιηθεί στις 29 και 30 Νοεμβρίου 2025 στο ξενοδοχείο Τιτάνια, υπό την αιγίδα των Υπουργείων Υγείας Ελλάδας και Κύπρου. Η διοργάνωση στοχεύει να αναδείξει τον καθοριστικό ρόλο των νοσηλευτών στη φροντίδα των ασθενών με θαλασσαιμία και δρεπανοκυτταρική νόσο, παθήσεις που απαιτούν εξειδικευμένη γνώση, συνεχή παρακολούθηση και υψηλό επίπεδο κλινικής επάρκειας. Η ΔΟΘ επισημαίνει ότι η νοσηλευτική συμβολή δεν περιορίζεται στην τεχνική διάσταση της φροντίδας, αλλά επεκτείνεται στην ψυχολογική και κοινωνική υποστήριξη των ασθενών και των οικογενειών τους.
Εκπαίδευση, σύγχρονες πρακτικές και διεθνής εμπειρία
Το πρόγραμμα του εργαστηρίου περιλαμβάνει εισηγήσεις από διεθνές πάνελ ειδικών, οι οποίοι θα παρουσιάσουν τις νεότερες θεραπευτικές προσεγγίσεις, τις απαιτήσεις της μακροχρόνιας φροντίδας και τις προκλήσεις που αντιμετωπίζουν τα συστήματα υγείας σε διαφορετικές χώρες. Ιδιαίτερη έμφαση θα δοθεί στη διαχείριση κρίσιμων επιπλοκών, στην παρακολούθηση των ασθενών με χρόνια νοσήματα και στη σημασία της διεπιστημονικής συνεργασίας. Στόχος είναι η ενίσχυση των δεξιοτήτων των νοσηλευτών και η αναβάθμιση της ποιότητας φροντίδας που παρέχεται σε ασθενείς με αιμοσφαιρινοπάθειες.
Νέα έκδοση του Οδηγού Νοσηλευτικής για τις Αιμοσφαιρινοπάθειες
Στο πλαίσιο του εργαστηρίου θα παρουσιαστεί η πλήρως ανανεωμένη έκδοση του «Οδηγού Νοσηλευτικής για τις Αιμοσφαιρινοπάθειες» της ΔΟΘ, η οποία ενσωματώνει τις πιο πρόσφατες επιστημονικές εξελίξεις και είναι πλέον διαθέσιμη και στην ελληνική γλώσσα. Η έκδοση θα διανεμηθεί στους συμμετέχοντες, προσφέροντας ένα σύγχρονο εργαλείο κλινικής υποστήριξης και συνεχιζόμενης επαγγελματικής ανάπτυξης.
Η πρωτοβουλία στοχεύει να ενισχύσει την εκπαίδευση όσων βρίσκονται στην πρώτη γραμμή της φροντίδας και να προωθήσει μια πιο ολοκληρωμένη και ανθρώπινη προσέγγιση στη διαχείριση των αιμοσφαιρινοπαθειών.

Comments (0)